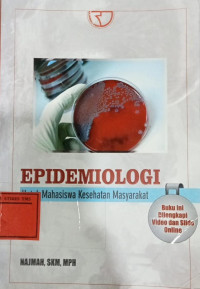
Image of Epidemiologi : Untuk Mahasiswa Kesehatan Masyarakat

Detail Cantuman
Pencarian Spesifik
Text
Epidemiologi : Untuk Mahasiswa Kesehatan Masyarakat
Tidak Tersedia Deskripsi
Ketersediaan
| B1600230 | Tersedia | ||
| B1600231 | Tersedia | ||
| B1600449 | Tersedia |
Informasi Detail
| Judul Seri |
-
|
|---|---|
| No. Panggil |
-
|
| Penerbit | RajaGrafindo Persada : Jakarta., 2015 |
| Deskripsi Fisik |
-
|
| Bahasa |
Indonesia
|
| ISBN/ISSN |
978-979-769-827-0
|
| Klasifikasi |
614.4
|
| Tipe Isi |
-
|
| Tipe Media |
-
|
|---|---|
| Tipe Pembawa |
-
|
| Edisi |
-
|
| Subjek |
-
|
| Info Detail Spesifik |
-
|
| Pernyataan Tanggungjawab |
Najmah
|
Versi lain/terkait
Tidak tersedia versi lain